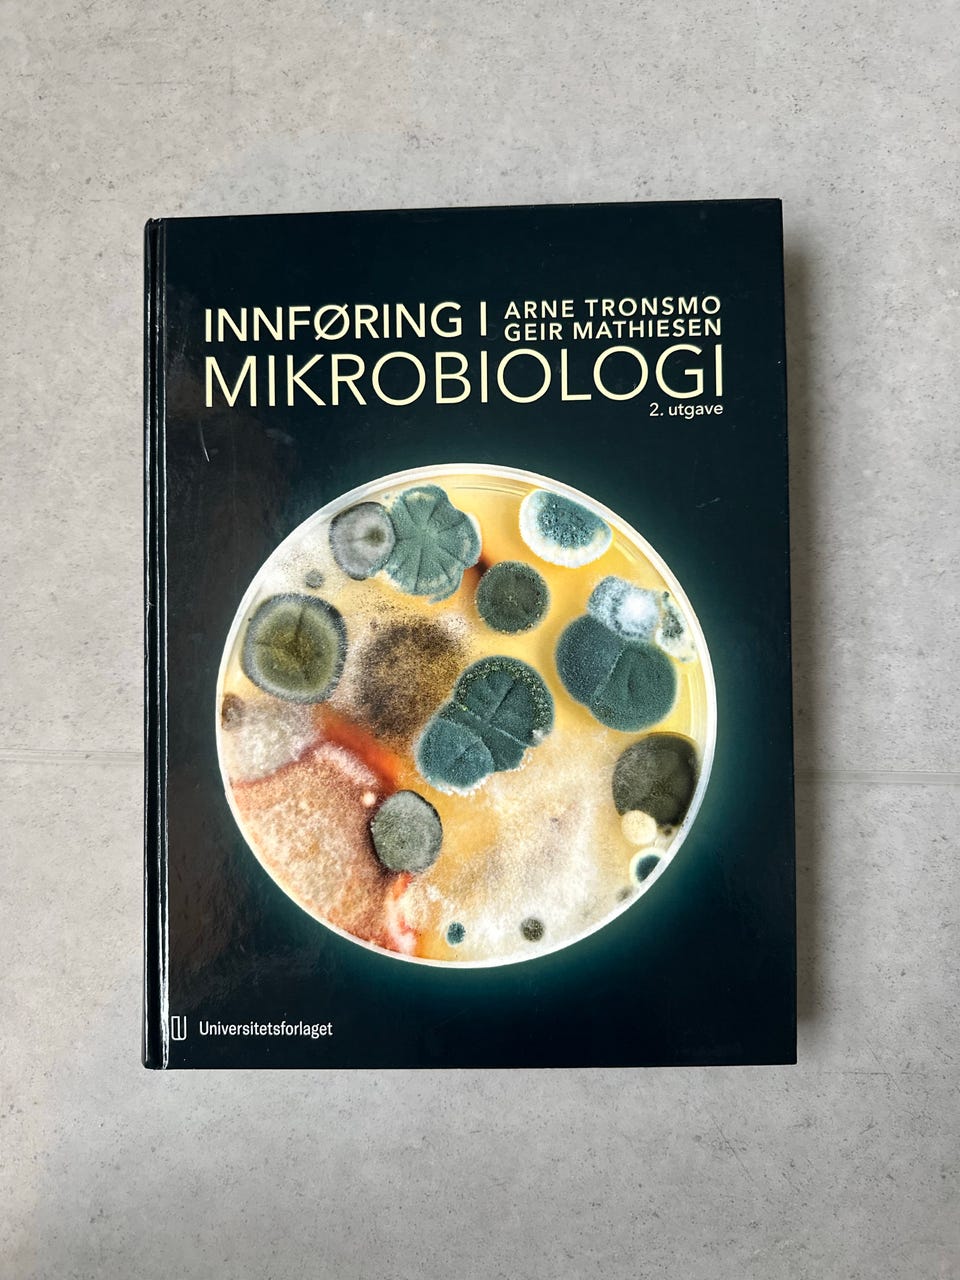
Galleribilde

Bildegalleri
(1/1)
Innføring i mikrobiologi
Til salgs
450 kr
Gratis frakt + Trygg betaling 48 kr
Trygg handel med Fiks ferdig
Etter levering har du 24 timer til å se over varen. Hvis det er noe galt med varen, får du pengene dine tilbake.
Beskrivelse av varen
Tilstand: Som ny - Ikke synlig brukt
Emne: Biologi
Selger boken Innføring i mikrobiologi av Arne Tronsmo og Geir Mathiesen. Boken er meget pent brukt og det er ingen markeringer i den. Kjøpt ny i 2024.
ISBN: 978-82-15-06880-0
NB: Knappen for å vise hele beskrivelsen har kun en visuell effekt.
Brukerprofil

Du må være logget inn for å se brukerprofiler og sende meldinger.
Logg innAnnonsens metadata
Sist endret: 24.5.2026 kl. 10:22 ・ FINN-kode: 445954614